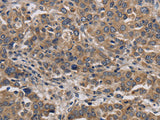
KIF22 Polyclonal Antibody Store at -20°C

KIF22 Polyclonal Antibody Store at -20°C
SKU: E-AB-13363-200
KIF22 Polyclonal Antibody Store at -20°C
| SKU # | E-AB-13363 |
| Reactivity | Human |
| Host | Rabbit |
| Applications | IHC |
Product Details
| Isotype | IgG |
| Host | Rabbit |
| Reactivity | Human |
| Applications | IHC |
| Clonality | Polyclonal |
| Immunogen | Synthetic peptide of human KIF22 |
| Abbre | KIF22 |
| Synonyms | A 328A3.2, KID, KIF 22, KIF22, Kinesin family member 22, Kinesin like 4, Kinesin like DNA binding protein, Kinesin like DNA binding protein pseudogene, Kinesin like protein 4, Kinesin like protein KIF22, Kinesin-like DNA-binding protein, Kinesin-like protein 4, kif22 |
| Swissprot | |
| Cellular Localization | Nucleus. Cytoplasm>cytoskeleton. |
| Concentration | 0.7 mg/mL |
| Buffer | Phosphate buffered solution, pH 7.4, containing 0.05% stabilizer and 50% glycerol. |
| Purification Method | Affinity purification |
| Research Areas | Signal Transduction |
| Conjugation | Unconjugated |
| Storage | Store at -20°C Valid for 12 months. Avoid freeze / thaw cycles. |
| Shipping | The product is shipped with ice pack, upon receipt, store it immediately at the temperature recommended. |
Related Reagents
| Applications | Recommended Dilution |
| IHC | 1:50-1:200 |
Background
The protein encoded by this gene is a member of the kinesin-like protein family. The family members are microtubule-dependent molecular motors that transport organelles within cells and move chromosomes during cell division. The C-terminal half of this protein has been shown to bind DNA. Studies with the Xenopus homolog suggests its essential role in metaphase chromosome alignment and maintenance. Alternatively spliced transcript variants encoding different isoforms have been found for this gene.